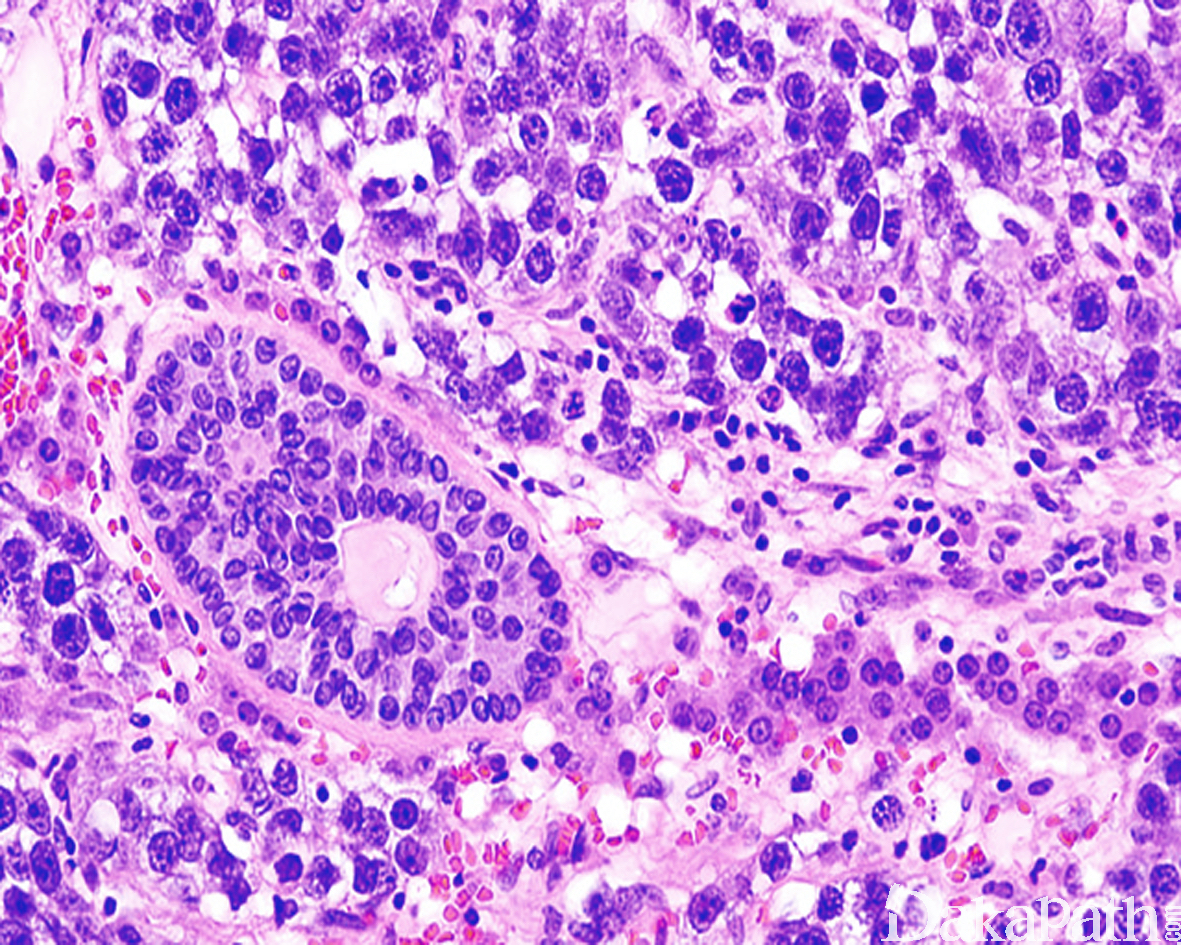

睾丸性腺母细胞瘤
Testicular Gonadoblastoma
概述:
肿瘤由生殖细胞和性索细胞两种细胞构成,生殖细胞成分类似于原位生殖细胞肿瘤,性索细胞类似于不成熟粒层细胞。
发病部位: 睾丸
诊断要点:
罕见,常因生殖器官性别特征不明确在新生儿期被发现。肿瘤质硬,黄-褐色,切面颗粒状或砂砾状;
镜下见肿瘤由多个分散的圆形细胞巢构成,巢内有生殖细胞、小的间质细胞及常伴钙化的圆形基底膜样物沉积,钙化可呈砂砾体样,也可融合成大的桑椹样聚集灶;
最少部分生殖细胞为肿瘤性增生,类似于管内生殖细胞肿瘤,细胞多角形,胞浆透亮,核成角,具 1 个或多个核仁;其它生殖细胞呈精母细胞样,浆少、染色质细颗粒状或丝状,核仁不清楚;不同病例这两种细胞比例变化较大;
性索细胞胞质少,核成角,可呈栅栏状排列于细胞巢的边缘,花环样围绕基底膜样物周围(Call-Exner 小体),或围绕单一生殖细胞排列(卵泡样结构);
偶尔细胞退行性变,仅剩下特征性的钙化物,称为退行性性腺母细胞瘤;
在性腺母细胞瘤的背景中可发生浸润性生殖细胞肿瘤。
免疫组织化学染色:
生殖细胞不同程度表达 PLAP、OCT3/4. NANOG、AP-2γ、 VASA、TSPY、CD117. KIT-L,性索细胞表达核 FOXL2. calretinin 和 Inhibin,弱表达 SOX9。
鉴别诊断:
支持细胞结节伴小管内生殖细胞肿瘤 :小管内生殖细胞肿瘤有时可累及支持细胞结节,通常为局灶累及支持细胞结界内,与性腺母细胞瘤中的生殖细胞呈散在弥漫分布于性索细胞之间不同。
精原细胞瘤 :性母细胞瘤存在性索成分(α-inhibin、calretinin、FOXL2 阳性),无淋巴细胞浸润等可与精原细胞瘤鉴别。
预后:
单纯的性腺母细胞瘤切除即可治愈,伴浸润性生殖细胞肿瘤者预后取决于浸润性成分的组成成分和分期
治疗:
双侧性腺切除
病例报道:
Dysgerminomas (seminomas) in genetic males with female phenotype. Onecaseof gonadal dysgenesis andgonadoblastomaand one oftesticularfeminization.
参考文献:
Ulbright TM, Young RH.
Semin Diagn Pathol. 2014 Sep;31(5):427-40. doi: 10.1053/j.semdp.2014.07.001. Epub 2014 Jul 18.